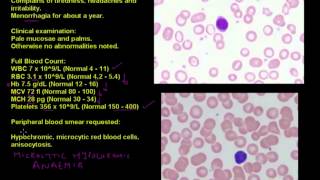
Anaemia in a young woman - Haematology case studies

Decade - Anaemia

Anaemia (anemia) - classification (microcytic, normocytic and macrocytic) and pathophysiology

Hematology | Types of Anemias

Iron Deficiency: Short & Long Term Effects | Well, Actually | Ep.1

Anemia (Types, Findings, Lab Values)

Living with Iron Deficiency: It doesn't matter what you do, you just feel tired.

Iron Deficiency | Cells | Biology | FuseSchool

Iron Deficiency Anemia in GI Disorders: Introduction & Case Presentations

Health : Iron deficiency in children, symptoms and cure
Anaemia in a young woman - Haematology case studies

Hematinic (Part-01)= Basic Introduction to Anaemia (Anemia) By Solution Pharmacy (HINDI)

A Color-Based, Disposable Anemia Test

Red Blood Cells | RBC | Erythrocytes | Erthropoeisis | Hematology

Aplastic Anaemia : Definition, Aetiology, Clinical Features, Diagnosis, Treatment, Prognosis (HD)

Iron & Iron Deficiency Anemia Part 3

Anemia: differential diagnosis

Anemia Case Study: Lab Interpretation for New Nurse Practitioners

SEVERE ANEMIA - short physical examination,IRON DEFICIENCY ANEMIA,NUTRITIONAL ANEMIA

Iron-deficiency Anemia: Prevention and Management – Pediatric Nursing | Lecturio Nursing

Anaemia
Recent comments